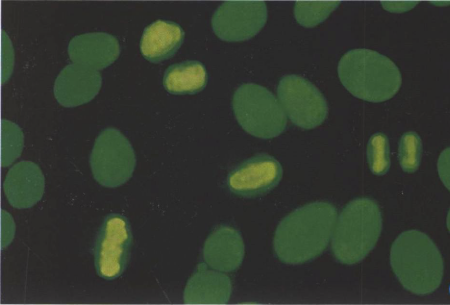

笨笨们的提问Web用户
Q
曾丽琼
2026年03月13日 18:18
问题编号: 40990
女性患者,植发3天后头部及颈出现红肿、皮疹、水疱,期间无接触其他化学物品,则与该症状相关的是
A.IgE
B.IgM
C.IgG
D.IgD
E.OT皮试
A.IgE
B.IgM
C.IgG
D.IgD
E.OT皮试
问1:答案:A. IgE
题干分析
植发后3天内出现:
红肿、皮疹、水疱
无其他化学品接触
→ 典型 Ⅰ型超敏反应(速发型过敏)
核心考点
• Ⅰ型超敏反应 → 介导抗体:IgE
• 表现:荨麻疹、皮疹、瘙痒、水肿、水疱
过敏快发找 IgE
Q
WyuEe
2026年03月13日 17:12
问题编号: 33022
下列试验中血标本受溶血影响最小的是
A.K+测定
B.LD测定
C.血清铁测定
D.Na+测定
E.AST测定
A.K+测定
B.LD测定
C.血清铁测定
D.Na+测定
E.AST测定
问1:为什么不选血清铁
Q
萌萌180
2026年03月13日 16:50
问题编号: 38768
下列不属于微量元素的是
A.锌
B.铜
C.钙
D.镉
E.碘
A.锌
B.铜
C.钙
D.镉
E.碘
问1:镉是人体微量元素吗
Q
曾丽琼
2026年03月13日 13:10
问题编号: 39421
阴道常见的炎症是
A.非特异性阴道炎
B.滴虫性阴道炎
C.阿米巴性阴道炎
D.嗜血杆菌性阴道炎
E.特异性阴道炎
A.非特异性阴道炎
B.滴虫性阴道炎
C.阿米巴性阴道炎
D.嗜血杆菌性阴道炎
E.特异性阴道炎
问1:答案:B. 滴虫性阴道炎
阴道炎症中最常见的是:滴虫性阴道炎。
Q
12528722981
2026年03月13日 12:30
问题编号: 41993
不能用于测定HbA1C的方法是
A.亲和层析法
B.离子交换层析法
C.电泳法
D.酶法
E.比浊法
A.亲和层析法
B.离子交换层析法
C.电泳法
D.酶法
E.比浊法
问1:为什么是酶法,我们糖化血红蛋白的检测方法就是酶法呀
Q
KM
2026年03月13日 10:48
问题编号: 43838
骨髓涂片中见到巨大原始红细胞对哪种疾病具有提示性诊断价值
A.纯红细胞再生障碍性贫血
B.再生障碍性贫血
C.巨幼细胞性贫血
D.再生障碍危象
E.铁粒幼细胞贫血
A.纯红细胞再生障碍性贫血
B.再生障碍性贫血
C.巨幼细胞性贫血
D.再生障碍危象
E.铁粒幼细胞贫血
问1:C错在哪
Q
KM
2026年03月13日 10:30
问题编号: 45168
患者,皮疹4天入院,体检:体温39.1摄氏度,全身皮肤有散在的斑丘疹和红斑疹。浅表淋巴结触及。血常规:WBC3.8X10^9/L,PLT78X10^9/L。最可能的诊断是
A.流行性出血热
B.伤寒
C.登革热
D.钩端螺旋体病
E.病毒性肝炎
A.流行性出血热
B.伤寒
C.登革热
D.钩端螺旋体病
E.病毒性肝炎
问1:C错在哪?
Q
KM
2026年03月13日 00:49
问题编号: 46361
患者,女,65岁。宫颈癌术后,伤口处插导管引流,术后2天开始出现寒战、高热和低血压。实验室检查:白细胞18×10^9/L,中性粒细胞90%,CRP152mg/L,PCT20ng/ml。连续使用抗生素没有好转,伤口愈合后拔除导管,患者还是持续发热。
导致该患者菌群失调的原因不包括
A. 长期使用放疗药物造成菌群失调
B. 机体免疫力丧失或缺乏
C. 长期使用抗生素
D. 外源微生物感染
E. 慢性消耗性疾病
导致该患者菌群失调的原因不包括
A. 长期使用放疗药物造成菌群失调
B. 机体免疫力丧失或缺乏
C. 长期使用抗生素
D. 外源微生物感染
E. 慢性消耗性疾病
问1:菌群失调不是内源性的感染吗
Q
KM
2026年03月13日 00:40
问题编号: 46357
患者,女,60岁。头晕3个月,贫血近1年。外周血检查:Hb75g/L,RBC2.9×10^12/L,HCT0.261,ESR3mm/h,外周血涂片可见红细胞大小不均,中央淡染区扩大。
其红细胞直方图曲线显示为
A. 主峰左移,RDW增宽
B. 主峰左移,RDW正常
C. 主峰右移,RDW增宽
D. 主峰正常,RDW正常
E. 主峰正常,RDW增宽
其红细胞直方图曲线显示为
A. 主峰左移,RDW增宽
B. 主峰左移,RDW正常
C. 主峰右移,RDW增宽
D. 主峰正常,RDW正常
E. 主峰正常,RDW增宽
问1:MCV是90 主峰不是正常吗
Q
KM
2026年03月13日 00:38
问题编号: 46355
温氏法测Hct,离心后自上而下分层,正确的是
A. 血浆、血小板和白细胞、有核红细胞、还原红细胞、带氧红细胞
B. 血浆、白细胞、血小板和有核红细胞、还原红细胞层、带氧红细胞
C. 血浆、血小板、白细胞和还原红细胞、有核红细胞、带氧红细胞
D. 血浆、血小板、白细胞和有核红细胞、还原红细胞层、带氧红细胞
E. 血浆、血小板、白细胞和带氧红细胞,有核红细胞,还原红细胞层
A. 血浆、血小板和白细胞、有核红细胞、还原红细胞、带氧红细胞
B. 血浆、白细胞、血小板和有核红细胞、还原红细胞层、带氧红细胞
C. 血浆、血小板、白细胞和还原红细胞、有核红细胞、带氧红细胞
D. 血浆、血小板、白细胞和有核红细胞、还原红细胞层、带氧红细胞
E. 血浆、血小板、白细胞和带氧红细胞,有核红细胞,还原红细胞层
问1:A,D不一样吗
Q
KM
2026年03月13日 00:18
问题编号: 46334
患者,女,45岁。临床表现为周期性深呼吸,疲乏感,动脉血气结果:pH7.15,SB20mmol/L,PCO₂30mmHg,BE5mmol/L,AB19mmol/L,考虑为
A. 代偿型代谢性酸中毒
B. 代偿型呼吸性酸中毒
C. 失代偿型呼吸性碱中毒
D. 代偿型代谢性碱中毒
E. 失代偿型代谢性酸中毒
A. 代偿型代谢性酸中毒
B. 代偿型呼吸性酸中毒
C. 失代偿型呼吸性碱中毒
D. 代偿型代谢性碱中毒
E. 失代偿型代谢性酸中毒
问1:酸碱平衡紊乱的代偿和失代偿怎么判断
Q
ShangLK
2026年03月12日 22:57
问题编号: 41330
下列不是属于细胞质内成分的是
A.核糖体
B.内含体
C.核质
D.中介体
E.质粒
A.核糖体
B.内含体
C.核质
D.中介体
E.质粒
问1:笔记和答案不对
Q
葫芦
2026年03月12日 21:27
问题编号: 42261
引起中枢神经系统感染的真核细胞型微生物是
A.狂犬病病毒
B.新生隐球菌
C.乙型脑炎病毒
D.脑膜炎奈瑟菌
E.脊髓灰质炎病毒
A.狂犬病病毒
B.新生隐球菌
C.乙型脑炎病毒
D.脑膜炎奈瑟菌
E.脊髓灰质炎病毒
问1:D不得吗?它们怎么区分这个感觉好像
Q
葫芦
2026年03月12日 21:04
问题编号: 42320
红细胞内充满网状物,似丝状球体,主要见于骨髓内,此网织红细胞为
A.0型
B.I型
C.II型
D.III型
E.IV型
A.0型
B.I型
C.II型
D.III型
E.IV型
问1:有0型?
Q
葫芦
2026年03月12日 21:00
问题编号: 42311
患者,空腹血标本生化检查结果为: TG 3.78mmol/L, CHO 4.91mmol/L,前β-脂蛋白增高,β-脂蛋白正常,乳糜微粒阴性,血清浑浊状,按WHO标准,其高脂蛋白血症分型属于
A.I型高脂蛋白血症
B.IIa型高脂蛋白血症
C.III型高脂蛋白血症
D.IV型高脂蛋白血症
E.IIb型高脂蛋白血症
A.I型高脂蛋白血症
B.IIa型高脂蛋白血症
C.III型高脂蛋白血症
D.IV型高脂蛋白血症
E.IIb型高脂蛋白血症
问1:怎么知道是几型?
Q
葫芦
2026年03月12日 20:18
问题编号: 42279
某患者干化学尿液检测蛋白阳性,沉渣检查可见大量白细胞。可能的疾病是
A.慢性肾小球肾炎
B.急性肾小球肾炎
C.肾病综合征
D.肾结石
E.肾盂肾炎
A.慢性肾小球肾炎
B.急性肾小球肾炎
C.肾病综合征
D.肾结石
E.肾盂肾炎
问1:老师肾病综合症和和肾盂肾炎怎么区分?
Q
WyuEe
2026年03月12日 16:53
问题编号: 28512
白细胞总数与中性粒细胞百分率均增高同时杆状核粒细胞>10%并有少数晚幼粒细胞和中毒性改变,常表示()。
A.造血功能衰退
B.预后良好
C.感染严重
D.轻度感染
E.感染已近恢复期
A.造血功能衰退
B.预后良好
C.感染严重
D.轻度感染
E.感染已近恢复期
问1:百分比增高为什么不选预后良好
Q
葫芦
2026年03月12日 16:40
问题编号: 41389
蛋白质的一级结构是指
A.氨基酸种类的数量
B.分子中的各化学键
C.多肽链的数量
D.分子中的双键数
E.氨基酸残基的排列顺序
A.氨基酸种类的数量
B.分子中的各化学键
C.多肽链的数量
D.分子中的双键数
E.氨基酸残基的排列顺序
问1:二级结构呢?一共有几级
Q
WyuEe
2026年03月12日 16:11
问题编号: 35499
溶血性贫血患者抗红细胞抗体的检测
A.RAST
B.直接免疫荧光
C.间接免疫荧光
D.乳胶凝集试验
E.ELISA
A.RAST
B.直接免疫荧光
C.间接免疫荧光
D.乳胶凝集试验
E.ELISA
问1:为什么不选间接免疫荧光
Q
WyuEe
2026年03月12日 15:43
问题编号: 38628
患者女,56岁,风湿性关节炎患者,反复发作,其病理过程属于
A.Ⅰ型超敏反应
B.Ⅱ型超敏反应
C.Ⅲ型超敏反应
D.Ⅳ型超敏反应
E.应激反应
A.Ⅰ型超敏反应
B.Ⅱ型超敏反应
C.Ⅲ型超敏反应
D.Ⅳ型超敏反应
E.应激反应
问1:风湿性关节炎不是二型超敏反应吗,类风湿性关节炎是三型
Q
15319102221
2026年03月12日 01:58
问题编号: 40947
正常情况下,肝脏获得能量的主要代谢途径是
A.葡萄糖进行糖酵解氧化
B.脂肪酸氧化
C.葡萄糖的有氧氧化
D.磷酸戊糖途径氧化葡萄糖
E.丙酮酸还原为乳酸
A.葡萄糖进行糖酵解氧化
B.脂肪酸氧化
C.葡萄糖的有氧氧化
D.磷酸戊糖途径氧化葡萄糖
E.丙酮酸还原为乳酸
问1:题目不是说了,正常情况下而非饥饿状态 ,所以C更合理吧
Q
张严
2026年03月11日 23:06
问题编号: 2726
脑脊液第一管标本适合于( )。
A.寄生虫检查
B.化学检查或免疫学检查
C.理学和细胞学检查
D.病原生物学检查
E.颅内压测定
A.寄生虫检查
B.化学检查或免疫学检查
C.理学和细胞学检查
D.病原生物学检查
E.颅内压测定
问1:已经不选D了
Q
ShangLK
2026年03月11日 22:15
问题编号: 39306
为鉴别炭疽芽孢杆菌和类炭疽杆菌,将待检菌接种于含0.3U/ml青霉素的培养基上,35℃培养6小时后,培养物亚甲蓝染色显微镜下观察如图所示。由此可以判断此菌为

A.枯草芽孢杆菌
B.腊样芽孢杆菌
C.苏云金芽孢杆菌
D.炭疽芽孢杆菌
E.巨大芽孢杆菌

A.枯草芽孢杆菌
B.腊样芽孢杆菌
C.苏云金芽孢杆菌
D.炭疽芽孢杆菌
E.巨大芽孢杆菌
问1:没图
Q
KM
2026年03月11日 20:59
问题编号: 46251
可以利用吸附柱过滤的方法分离纯化细胞,其中最不容易分离的免疫细胞是
A. 单核细胞
B. 树突状细胞
C. 红细胞
D. T淋巴细胞
E. B淋巴细胞
A. 单核细胞
B. 树突状细胞
C. 红细胞
D. T淋巴细胞
E. B淋巴细胞
问1:粘附能力强不是不容易分离吗
Q
KM
2026年03月11日 20:44
问题编号: 46221
在测定肌酸激酶的试剂中加入N-乙酰半胱氨酸的目的是
A. 使酶分子有别构效应
B. 稳定酶活性中心
C. 去除腺甘激酶(AK)的影响
D. 硫基化合物是肌酸激酶底物之一
E. 除去肌酸激酶抑制剂
A. 使酶分子有别构效应
B. 稳定酶活性中心
C. 去除腺甘激酶(AK)的影响
D. 硫基化合物是肌酸激酶底物之一
E. 除去肌酸激酶抑制剂
问1:应该是B吧
Q
KM
2026年03月11日 19:59
问题编号: 46187
空肠弯曲菌和霍乱弧菌鉴别的方式
A. 革兰阴性弧菌
B. 5%O₂、85%N₂、10%CO₂的环境中生长
C. 42℃生长
D. 动力
E. 脲酶试验
A. 革兰阴性弧菌
B. 5%O₂、85%N₂、10%CO₂的环境中生长
C. 42℃生长
D. 动力
E. 脲酶试验
问1:霍乱弧菌16到44度都可以生长 这题应该选B吧
Q
15392703129
2026年03月11日 19:14
问题编号: 39306
为鉴别炭疽芽孢杆菌和类炭疽杆菌,将待检菌接种于含0.3U/ml青霉素的培养基上,35℃培养6小时后,培养物亚甲蓝染色显微镜下观察如图所示。由此可以判断此菌为

A.枯草芽孢杆菌
B.腊样芽孢杆菌
C.苏云金芽孢杆菌
D.炭疽芽孢杆菌
E.巨大芽孢杆菌

A.枯草芽孢杆菌
B.腊样芽孢杆菌
C.苏云金芽孢杆菌
D.炭疽芽孢杆菌
E.巨大芽孢杆菌
问1:没有图
Q
圆圆圈圈
2026年03月11日 18:03
问题编号: 43095
某校多名学生在食堂进餐后数小时出现恶心、呕吐症状。取剩余食物做细菌培养,培养物呈金黄色、可产生血浆凝固酶、可分解甘露醇。此菌的其他特点是
A.胆汁溶菌试验阳性
B.致病物质有SPA
C.不耐低温
D.人是其唯一宿主
E.可形成双层溶血环
A.胆汁溶菌试验阳性
B.致病物质有SPA
C.不耐低温
D.人是其唯一宿主
E.可形成双层溶血环
问1:为什么不是E
Q
圆圆圈圈
2026年03月11日 17:58
问题编号: 37988
可作为共同传播媒介物引起医院感染的为
A.患者
B.医院工作人员
C.探视者
D.陪同人员
E.未彻底消毒灭菌的血液制品
A.患者
B.医院工作人员
C.探视者
D.陪同人员
E.未彻底消毒灭菌的血液制品
问1:不是医护人员的手吗?
Q
KM
2026年03月11日 17:58
问题编号: 46141
酸中毒
A. 离子钙浓度升高,结合钙浓度降低
B. 血清总钙不变,结合钙浓度升高
C. 血清总钙不变,离子钙浓度升高
D. 血清总钙不变,离子钙浓度降低
E. 离子钙浓度升高,结合钙浓度升高
A. 离子钙浓度升高,结合钙浓度降低
B. 血清总钙不变,结合钙浓度升高
C. 血清总钙不变,离子钙浓度升高
D. 血清总钙不变,离子钙浓度降低
E. 离子钙浓度升高,结合钙浓度升高
问1:C错在哪里?
Q
KM
2026年03月11日 16:44
问题编号: 46111
用不同的ELISA试剂板在进行检测时,反应不同试剂板质量优劣的指标不包括
A. 空白值
B. 孔底透明检测
C. 吸附性能
D. 各板之间和同一板各孔之间性能比较
E. 脱吸附率
A. 空白值
B. 孔底透明检测
C. 吸附性能
D. 各板之间和同一板各孔之间性能比较
E. 脱吸附率
问1:A选项错在哪里?
Q
8468cl
2026年03月11日 16:05
问题编号: 42301
医疗卫生资源分配最基本的伦理原则是
A. 公平
B. 公正
C. 公用
D. 效用
E. 效益
A. 公平
B. 公正
C. 公用
D. 效用
E. 效益
问1:b选项是 公正
Q
曾丽琼
2026年03月11日 15:10
问题编号: 39014
表现为血清铁增加,总铁结合力减低的疾病是
A.溶血性贫血
B.缺铁性贫血
C.慢性疾病贫血
D.再生性障碍型贫血
E.铁粒幼细胞性贫血
A.溶血性贫血
B.缺铁性贫血
C.慢性疾病贫血
D.再生性障碍型贫血
E.铁粒幼细胞性贫血
问1:答案:A. 溶血性贫血
一句话记住
• 溶血性贫血:红细胞破坏多 → 铁释放多 → 血清铁↑,总铁结合力↓
• 铁粒幼细胞性贫血:血清铁↑↑,但总铁结合力正常或减低,不是典型“减低”为主
• 慢性病贫血:血清铁↓,总铁结合力↓
• 缺铁性贫血:血清铁↓,总铁结合力↑
所以这题选 A。
Q
8468cl
2026年03月11日 14:59
问题编号: 41950
某患者在经蚊虫叮咬后,出现寒战、发热出汗退热等症状,现怀疑疟原虫感染。
第1问:外周血图片如下所示,镜下所见疟原虫为

A.环状体
B.大滋养体
C.小滋养体
D.裂殖体
E.裂殖子
第1问:外周血图片如下所示,镜下所见疟原虫为

A.环状体
B.大滋养体
C.小滋养体
D.裂殖体
E.裂殖子
问1:无图片
Q
8468cl
2026年03月11日 14:57
问题编号: 41943
【病例】患者男,72岁。腰背部疼痛2余月就诊。查体:神清,贫血貌,腰背部压痛明显。实验室检查:红细胞3.2×10¹²/L,血红蛋白98g/L,白细胞8.2×10⁹/L,血涂片改变如图所示,X线检查示弥漫性骨质疏松。

第1问:该患者最可能的诊断是
A.白血病
B.多发性骨髓瘤
C.肾形贫血
D.慢性肾小球肾炎

第1问:该患者最可能的诊断是
A.白血病
B.多发性骨髓瘤
C.肾形贫血
D.慢性肾小球肾炎
问1:无图
Q
8468cl
2026年03月11日 14:56
问题编号: 41939
某患者,女性,20岁,四肢关节疼痛7月近日加重,来医院就诊,怀疑自身免疫病。
第3问:用免疫荧光法检测ANA有多种核型,下图属于

A.均质型
B.核膜型
C.胞质型
D.斑点型
E.核仁型
第3问:用免疫荧光法检测ANA有多种核型,下图属于
A.均质型
B.核膜型
C.胞质型
D.斑点型
E.核仁型
问1:无图片
Q
8455597
2026年03月11日 14:36
问题编号: 30690
某患者MCH为20pg,MCV为80fl,MCHC为250g/L,可能诊断为
A.巨幼细胞性贫血
B.正常细胞性贫血
C.单纯小细胞性贫血
D.小细胞低色素性贫血
E.缺铁性贫血
A.巨幼细胞性贫血
B.正常细胞性贫血
C.单纯小细胞性贫血
D.小细胞低色素性贫血
E.缺铁性贫血
问1:这题目有有问题,MCV是80,是正细胞,答案是小细胞
Q
凤姐
2026年03月11日 11:14
问题编号: 42583
红细胞不易形成缗钱状排列的血液因素是
A.纤维蛋白原增高
B.胆固醇增高
C.球蛋白增高
D.血脂增高
E.卵磷脂增高
A.纤维蛋白原增高
B.胆固醇增高
C.球蛋白增高
D.血脂增高
E.卵磷脂增高
问1:不明白?没有解释,可以解释一下吗?
Q
15319102221
2026年03月10日 17:58
问题编号: 34412
患者女,类风湿性因子阳性,怀疑为风湿性关节炎,欲进一步检查抗链球菌溶血素“O”,可采用下列哪种试验方法
A.红细胞凝集试验
B.免疫散射比浊试验
C.蛋白质沉淀反应
D.琼脂扩散试验
E.明胶凝集试验
A.红细胞凝集试验
B.免疫散射比浊试验
C.蛋白质沉淀反应
D.琼脂扩散试验
E.明胶凝集试验
问1:ASO实验 常用胶乳凝集实验还是免疫散射比浊?
Q
张严
2026年03月10日 16:19
问题编号: 8518
胰岛素的作用机制是
A.直接渗透到细胞内对糖代谢发挥作用
B.直接渗透到细胞内与蛋白结合发挥作用
C.与细胞膜上特殊蛋白受体结合,传递信息引起细胞内代谢途径到变化
D.与细胞膜上特殊蛋白受体结合,进入细胞对糖代谢发挥作用
E.与细胞膜上特殊蛋白受体结合,经过第二信使传递直接参与糖代谢的作用
A.直接渗透到细胞内对糖代谢发挥作用
B.直接渗透到细胞内与蛋白结合发挥作用
C.与细胞膜上特殊蛋白受体结合,传递信息引起细胞内代谢途径到变化
D.与细胞膜上特殊蛋白受体结合,进入细胞对糖代谢发挥作用
E.与细胞膜上特殊蛋白受体结合,经过第二信使传递直接参与糖代谢的作用
问1:这题选E???
问2:这题选E对吗
问2:这题选E对吗
Q
张严
2026年03月10日 00:47
问题编号: 5035
[患者男性,12岁。急起畏寒、高热,头痛、肌肉酸痛,并有鼻塞、流涕、咳嗽、咽干、咽痛。查体:T40℃,急性病容,鼻、咽部及结膜轻度充血。肺部可闻及干啰音。血常规显示白细数减少,淋巴细胞相对增加。]
有关该患者的治疗,错误的是
A.尽早使用抗病毒药物
B.加强支持治疗
C.使用阿司匹林对症治疗
D.明确细菌感染时应用抗生素
E.使用金刚烷胺治疗甲型流感病毒感染
有关该患者的治疗,错误的是
A.尽早使用抗病毒药物
B.加强支持治疗
C.使用阿司匹林对症治疗
D.明确细菌感染时应用抗生素
E.使用金刚烷胺治疗甲型流感病毒感染
问1:抗生素对病毒治疗无效
Q
15319102221
2026年03月09日 22:21
问题编号: 34489
放射免疫非竞争性结合分析法中常用放射性核素标记
A.标准品
B.待测抗原
C.抗体
D.沉淀剂
E.定量抗原
A.标准品
B.待测抗原
C.抗体
D.沉淀剂
E.定量抗原
问1:放免是竞争反应,标记定量抗原
Q
15319102221
2026年03月09日 22:11
问题编号: 34466
了解M蛋白的类型应做
A.蛋白电泳
B.免疫电泳
C.免疫固定电泳
D.免疫球蛋白定量
E.尿-本周蛋白检测
A.蛋白电泳
B.免疫电泳
C.免疫固定电泳
D.免疫球蛋白定量
E.尿-本周蛋白检测
问1:免疫电泳只能测出有无M蛋白 免疫固定电泳才是分型的
Q
葫芦
2026年03月09日 21:47
问题编号: 43690
患者女,28岁,因咳嗽、发热7天就诊。查体:体温37.8℃,右上肺闻及湿罗音。胸片示右肺上叶见片状阴影。结核菌素试验:红肿直径大于20mm。该患者可能为
A.注射过卡介苗
B.处于结核病活动期
C.处于结核病恢复期
D.处于结核分枝杆菌早期感染
E.对结核分枝杆菌无免疫力
A.注射过卡介苗
B.处于结核病活动期
C.处于结核病恢复期
D.处于结核分枝杆菌早期感染
E.对结核分枝杆菌无免疫力
问1:没解释
Q
葫芦
2026年03月09日 21:13
问题编号: 43664
关于前白蛋白的叙述错误的是
A.由肝脏合成
B.半衰期约12小时,较白蛋白短
C.反映营养不良和肝功能不全较白蛋白敏感
D.与视黄醇结合蛋白形成的复合物,具有运载维生素A的作用
E.急性炎症时,血浆水平上升
A.由肝脏合成
B.半衰期约12小时,较白蛋白短
C.反映营养不良和肝功能不全较白蛋白敏感
D.与视黄醇结合蛋白形成的复合物,具有运载维生素A的作用
E.急性炎症时,血浆水平上升
问1:为啥我看不懂解释
Q
li80138087
2026年03月09日 20:39
问题编号: 40505
患儿男,出生后3天,皮肤出现黄染,血型鉴定结果如表所示
--------------------
正定型反定型(红细胞)
--------------------
抗A抗B标准A标准B
--------------------
+---
--------------------
该患者正常的血型是
A.A型
B.B型
C.AB型
D.O型
E.A1B型
--------------------
正定型反定型(红细胞)
--------------------
抗A抗B标准A标准B
--------------------
+---
--------------------
该患者正常的血型是
A.A型
B.B型
C.AB型
D.O型
E.A1B型
问1:无图
Q
葫芦
2026年03月09日 19:39
问题编号: 42792
体育运动员兴奋剂检查时,尿标本适宜点防腐剂是
A.甲醛
B.磷酸
C.浓盐酸
D.碳酸钠
E.浓硫酸
A.甲醛
B.磷酸
C.浓盐酸
D.碳酸钠
E.浓硫酸
问1:为啥
Q
葫芦
2026年03月09日 17:23
问题编号: 42001
下列表示等臂染色体的是
A.t
B.inv
C.iso
D.ins
E.p
A.t
B.inv
C.iso
D.ins
E.p
问1:ins是什么
Q
18356376350
2026年03月09日 12:00
问题编号: 46463
一个酶活力的Katal单位是指
A. 在实验规定条件下,每分钟催化1mmol底物反应所需的酶量
B. 在特定条件下,每分钟催化1umol底物发生反应所需的酶量
C. 在37℃条件下,每分钟催化1umol底物发生反应所需的酶量
D. 在规定条件下,每秒钟催化1mol底物反应所需的酶量
E. 在最适条件下每小时催化1mol底物发生反应所需的酶量
A. 在实验规定条件下,每分钟催化1mmol底物反应所需的酶量
B. 在特定条件下,每分钟催化1umol底物发生反应所需的酶量
C. 在37℃条件下,每分钟催化1umol底物发生反应所需的酶量
D. 在规定条件下,每秒钟催化1mol底物反应所需的酶量
E. 在最适条件下每小时催化1mol底物发生反应所需的酶量
问1:你们选D其他的地方选B,有疑虑
Q
15021821575
2026年03月09日 10:59
问题编号: 40303
[患儿男,10岁。发热一周,并有咽喉痛,最近两天皮肤有皮疹。体检:颈部及腹股沟浅表淋巴结肿大,肝肋下lcm,脾肋下lcm。入院时血常规结果为:血红蛋白122g/L;白细胞15×lO^9/L,白细胞分类:中性成熟粒细胞18%,淋巴细胞76%,嗜酸性粒细胞2%,单核细胞4%,原始细胞未见,血小板数189×10^9/L。]
首先考虑下列
A.恶性淋巴瘤
B.急性淋巴细胞白血病
C.慢性淋巴细胞白血病
D.传染性单核细胞增多症
E.上呼吸道感染
首先考虑下列
A.恶性淋巴瘤
B.急性淋巴细胞白血病
C.慢性淋巴细胞白血病
D.传染性单核细胞增多症
E.上呼吸道感染
问1:为什么是传染性单核细胞增多症?
Q
吴雪玲
2026年03月08日 23:06
问题编号: 33197
肝炎
A.血清铁降低,总铁结合力增髙
B.血清铁增髙,总铁结合力降低
C.血清铁、总铁结合力均增髙
D.血淸铁、总铁结合力均降低
E.血淸铁增髙,总铁结合力正常
A.血清铁降低,总铁结合力增髙
B.血清铁增髙,总铁结合力降低
C.血清铁、总铁结合力均增髙
D.血淸铁、总铁结合力均降低
E.血淸铁增髙,总铁结合力正常
问1:解析和答案不配套
Q
曾丽琼
2026年03月08日 22:13
问题编号: 38822
常引起食物中毒的厌氧菌是
A.艰难梭菌
B.肉毒梭菌
C.破伤风梭菌
D.脆弱类杆菌
E.产气荚膜梭菌
A.艰难梭菌
B.肉毒梭菌
C.破伤风梭菌
D.脆弱类杆菌
E.产气荚膜梭菌
问1:这题考的是厌氧菌食物中毒,答案是:E. 产气荚膜梭菌
考点区分(必背)
• 产气荚膜梭菌:食物中毒(A型) + 气性坏疽
• 肉毒梭菌:肉毒中毒(神经毒素)
• 艰难梭菌:抗生素相关性腹泻
• 破伤风梭菌:破伤风
• 脆弱类杆菌:腹腔、盆腔感染
一句话记:
产气荚膜吃坏肚,肉毒中毒神经毒。
到底是不是B 还是E
Q
WyuEe
2026年03月08日 22:05
问题编号: 39334
通过接触感染的是
A.猪带绦虫
B.蛲虫
C.黑热病原虫
D.阴道毛滴虫
E.血吸虫
A.猪带绦虫
B.蛲虫
C.黑热病原虫
D.阴道毛滴虫
E.血吸虫
问1:为什么不选e
Q
刷题刷题
2026年03月08日 21:13
问题编号: 46673
患儿,男,10岁。发热1周,并有咽喉痛,咽峡炎。体检发现:颈部淋巴结肿大,扁桃体肿痛。血常规:RBC4.0×10^12/L,Hb130g/L,WBC12×10^9/L,PLT210×10^9/L。白细胞分类:中性成熟粒细胞81%,淋巴细胞13%,嗜酸性粒细胞2%,单核细胞4%,原始细胞未见。
血涂片检查最可能出现
A. 中毒颗粒和空泡变性
B. 原始及幼稚淋巴细胞
C. 卫星核淋巴细胞
D. 涂抹细胞
E. 异型淋巴细胞
血涂片检查最可能出现
A. 中毒颗粒和空泡变性
B. 原始及幼稚淋巴细胞
C. 卫星核淋巴细胞
D. 涂抹细胞
E. 异型淋巴细胞
问1:本题中性粒细胞明显增多,淋巴细胞比例降低,应该是倾向于细菌感染吧。
Q
曾丽琼
2026年03月08日 18:19
问题编号: 38782
不影响离子选择性电极法的因素是
A.离子强度
B.溶液的pH值和温度
C.20单位肝素
D.干扰离子
E.标本稀释度
A.离子强度
B.溶液的pH值和温度
C.20单位肝素
D.干扰离子
E.标本稀释度
问1:答案:C. 20单位肝素
考点速记
离子选择性电极法(ISE)测电解质受这些影响:
• 温度、pH、离子强度
• 干扰离子
• 标本稀释度
肝素(合理剂量)不影响,是常用抗凝剂。
这是豆包答案
Q
葫芦
2026年03月08日 18:09
问题编号: 42704
患者女,31岁。因乏力就诊,Hb102g/L,MCV75fl,血清铁7.91μmol/L,总铁结合力75.98μmol/L,可能的诊断为
A.铁粒幼细胞贫血
B.珠蛋白生成障碍性贫血
C.巨幼红细胞贫血
D.缺铁性贫血
E.骨骼增生异常综合征
A.铁粒幼细胞贫血
B.珠蛋白生成障碍性贫血
C.巨幼红细胞贫血
D.缺铁性贫血
E.骨骼增生异常综合征
问1:缺铁性贫血和铁力幼细胞贫血怎么区分?
Q
My1314521
2026年03月08日 16:54
问题编号: 40189
革兰阴性杆菌,厌氧不生长,能产生自溶酶,可被胆汁溶解,在急性感染标本中菌体呈
短小球杆菌,恢复期病灶中呈多形性,该细菌是
A.白喉棒状杆菌
B.流感嗜血杆菌
C.脆弱类杆菌
D.普通变形杆菌
E.脑膜炎奈瑟菌
短小球杆菌,恢复期病灶中呈多形性,该细菌是
A.白喉棒状杆菌
B.流感嗜血杆菌
C.脆弱类杆菌
D.普通变形杆菌
E.脑膜炎奈瑟菌
问1:答案跟最后解析的说的不一样 答案是B 解析说的是对的但是写的是C
Q
张严
2026年03月08日 16:45
问题编号: 10388
关于心肌肌钙蛋白的叙述,错误的是
A.应用于非ST段抬高型心梗的诊断和预后评估
B.心梗发生后1~3小时可见升高
C.用于再梗的诊断价值大
D.主要用于估计梗死面积和心功能
E.围手术期心脏受损程度评估价值不大
A.应用于非ST段抬高型心梗的诊断和预后评估
B.心梗发生后1~3小时可见升高
C.用于再梗的诊断价值大
D.主要用于估计梗死面积和心功能
E.围手术期心脏受损程度评估价值不大
问1:Mb不是1-3小时开始升高吗,肌钙蛋白要3小时后
Q
葫芦
2026年03月08日 16:06
问题编号: 41907
与以下疾病相匹配的骨髓增生状态分别是。IDA患者,RBC3.0X1012/L
A.增生活跃
B.增生极度活跃
C.增生明显活跃
D.增生减低
E.增生极度减低
A.增生活跃
B.增生极度活跃
C.增生明显活跃
D.增生减低
E.增生极度减低
问1:重哪里看出来
Q
15392703129
2026年03月08日 15:11
问题编号: 42245
患者,女,38岁。自诉有腥臭味的灰白色的白带,量多,阴道瘙痒。白带检查:外观稀薄均匀, pH5.4,胺试验阳性,取分泌物染色,镜下如图所示。提示患者感染

A. 白色念珠菌
B. 淋病奈瑟菌
C. 大肠埃希菌
D. 阴道加德纳菌
E. 金黄色葡萄球菌

A. 白色念珠菌
B. 淋病奈瑟菌
C. 大肠埃希菌
D. 阴道加德纳菌
E. 金黄色葡萄球菌
问1:没有图片
Q
KM
2026年03月08日 13:06
问题编号: 46683
一个冠心病的患者,消化道感染,剧烈腹绞痛、腹泻,排蛋花汤样黏液便。查体:T36.3℃,P70次/分,BP12/7kPa。粪便培养可见革兰阳性粗杆菌,有芽孢位于次极端。
确诊的指标是
A. 生化检查
B. 代谢物检测
C. 毒素检测
D. 细菌培养
E. 免疫检测
确诊的指标是
A. 生化检查
B. 代谢物检测
C. 毒素检测
D. 细菌培养
E. 免疫检测
问1:为什么不选D
Q
KM
2026年03月08日 13:06
问题编号: 46656
患者,女,35岁。双下肢浮肿2周,血压150/95mmHg,蛋白尿(+++),尿糖(+),白蛋白30g/L,血肌酐160umol/L。
如果该患者唾液/胰腺淀粉酶清除率大于1,说明患者蛋白尿出现的原因是
A. 肾小球分子屏障功能减低
B. 肾小球电荷屏障功能减低
C. 肾小球滤过膜孔径变大
D. 肾小管重吸收功能减低
E. 肾小管有严重病变
如果该患者唾液/胰腺淀粉酶清除率大于1,说明患者蛋白尿出现的原因是
A. 肾小球分子屏障功能减低
B. 肾小球电荷屏障功能减低
C. 肾小球滤过膜孔径变大
D. 肾小管重吸收功能减低
E. 肾小管有严重病变
问1:这题应该是B吧
Q
张严
2026年03月08日 12:41
问题编号: 11404
如图3所示,该虫卵是

A.钩虫卵
B.蛔虫卵
C.鞭虫卵
D.血吸虫卵
E.蛲虫卵

A.钩虫卵
B.蛔虫卵
C.鞭虫卵
D.血吸虫卵
E.蛲虫卵
问1:没有图
Q
张严
2026年03月08日 12:37
问题编号: 11391
外周血涂片如图1所示,箭头指示的细胞是

A.中性粒细胞
B.嗜碱性粒细胞
C.嗜酸性粒细胞
D.淋巴细胞
E.单核细胞

A.中性粒细胞
B.嗜碱性粒细胞
C.嗜酸性粒细胞
D.淋巴细胞
E.单核细胞
问1:没有图片
Q
张严
2026年03月08日 12:27
问题编号: 8449
破伤风梭菌产生
A.内毒素
B.外毒素
C.神经毒素
D.细胞毒素
E.红疹毒素
A.内毒素
B.外毒素
C.神经毒素
D.细胞毒素
E.红疹毒素
问1:神经毒素
Q
KM
2026年03月08日 07:48
问题编号: 46607
细菌学的室间质量评价的指标不包括
A. 细菌的耐药率
B. 细菌分离的成功率
C. 精密度的高低
D. 盲点试验
E. 操作的熟练程度
A. 细菌的耐药率
B. 细菌分离的成功率
C. 精密度的高低
D. 盲点试验
E. 操作的熟练程度
问1:这题答案不对吧 是不是该选A
Q
15319102221
2026年03月08日 00:44
问题编号: 34287
能阻断小鼠骨髓瘤细胞DNA合成的物质是
A.8-氮鸟嘌呤
B.胸腺嘧啶核苷
C.甲氨蝶呤
D.次黄嘌呤
E.鸟嘌呤
A.8-氮鸟嘌呤
B.胸腺嘧啶核苷
C.甲氨蝶呤
D.次黄嘌呤
E.鸟嘌呤
问1:不是A嘛?
Q
15319102221
2026年03月08日 00:19
问题编号: 34209
完全抗原的特征是
A.有抗原性,有免疫原性
B.有抗原性,有免疫反应性
C.有免疫原性,无抗原性
D.无免疫原性,有抗原性
E.必须与载体结合才具有免疫原性
A.有抗原性,有免疫原性
B.有抗原性,有免疫反应性
C.有免疫原性,无抗原性
D.无免疫原性,有抗原性
E.必须与载体结合才具有免疫原性
问1:B为啥不对
Q
圆圆圈圈
2026年03月07日 23:16
问题编号: 40843
AIDS鉴定一般不做
A.类风湿因子
B.ANA
C.抗乙酰胆碱受体检查
D.白细胞分类计数
E.ENA抗体检测
A.类风湿因子
B.ANA
C.抗乙酰胆碱受体检查
D.白细胞分类计数
E.ENA抗体检测
问1:艾滋和类风湿因子有什么关系
Q
KM
2026年03月07日 22:15
问题编号: 46521
营养不良时以下哪个指标会减低
A. 血小板数
B. 白细胞数
C. 淋巴细胞数
D. 单核细胞数
E. CH50
A. 血小板数
B. 白细胞数
C. 淋巴细胞数
D. 单核细胞数
E. CH50
问1:CH50不是补体吗 这个怎么变化
Q
张严
2026年03月07日 22:09
问题编号: 11520

如图1所示最大的有核细胞是
A.吞噬细胞
B.破骨细胞
C.网状细胞
D.幼稚巨核细胞
E.颗粒性巨核细胞
问1:没有图
Q
张严
2026年03月07日 21:53
问题编号: 11505
关于引起菌群失调症原因的描述,不正确的是
A.不适当的抗菌药物治疗
B.患者免疫功能紊乱
C.垂体功能紊乱
D.外来菌的侵袭
E.医疗措施影响
A.不适当的抗菌药物治疗
B.患者免疫功能紊乱
C.垂体功能紊乱
D.外来菌的侵袭
E.医疗措施影响
问1:C应该是对的吧
Q
小彩子
2026年03月07日 21:48
问题编号: 43565
有关尿微量白蛋白(mAlb)测定的叙述,正确的是
A.试带法测定尿蛋白的敏感度较mAlb高
B.磺柳酸法测定尿蛋白的敏感度较mAlb高
C.mAlb是诊断糖尿病肾病的金指标
D.mAlb一次阳性即可诊斯
E.随机尿样中的浓度与肌酐比值完全可以代替尿mAlb的测定
A.试带法测定尿蛋白的敏感度较mAlb高
B.磺柳酸法测定尿蛋白的敏感度较mAlb高
C.mAlb是诊断糖尿病肾病的金指标
D.mAlb一次阳性即可诊斯
E.随机尿样中的浓度与肌酐比值完全可以代替尿mAlb的测定
问1:老师,其他地方刷到选E
Q
15021821575
2026年03月07日 21:01
问题编号: 39597
[患者女性,45岁。右肾结石病史5年,三天前突发高热,寒战,感全身不适,腰痛,并有尿频,尿急及排尿疼痛,查体:T39℃,右脊肋区压痛及叩击痛,尿检:外观混浊,RBC:8/HP,WBC:30/HP,临床诊断为急性肾盂肾炎。]
若进行清洁中段尿培养,请问具有尿路感染诊断意义的细菌数为
A.>10^3CFU/ml
B.>IO^4CFU/ml
C.10^4~10^5CFU/ml
D.<lO^5CFU/ml
E.>10^5CFU/ml
若进行清洁中段尿培养,请问具有尿路感染诊断意义的细菌数为
A.>10^3CFU/ml
B.>IO^4CFU/ml
C.10^4~10^5CFU/ml
D.<lO^5CFU/ml
E.>10^5CFU/ml
问1:10cfu?
Q
az666
2026年03月07日 20:06
问题编号: 42330
正常粪便中可见
A.白细胞
B.红细胞
C.吞噬细胞
D.肠上皮细胞
E.浆细胞
A.白细胞
B.红细胞
C.吞噬细胞
D.肠上皮细胞
E.浆细胞
问1:无解析
Q
张严
2026年03月07日 19:36
问题编号: 8535
患者女,30岁。血常规检查结果: Hb 91 g/L,MCV 78fl, RDW 23.5%。提示红细胞
A.形状正常
B.大小一致
C.小细胞低色素改变
D.巨幼变
E.单纯小细胞改变
A.形状正常
B.大小一致
C.小细胞低色素改变
D.巨幼变
E.单纯小细胞改变
问1:这题选E吗?
Q
az666
2026年03月07日 19:22
问题编号: 42301
医疗卫生资源分配最基本的伦理原则是
A. 公平
B. 公正
C. 公用
D. 效用
E. 效益
A. 公平
B. 公正
C. 公用
D. 效用
E. 效益
问1:答案设置错误
Q
曾丽琼
2026年03月07日 18:30
问题编号: 40918
小分子物质属于
A.半抗原
B.颗粒抗原
C.可溶性抗原
D.特异性抗原
E.多种抗原
A.半抗原
B.颗粒抗原
C.可溶性抗原
D.特异性抗原
E.多种抗原
问1:正确答案:C. 可溶性抗原
解析:
小分子物质、蛋白质、多糖等溶解在液体中的抗原,属于可溶性抗原。
• 半抗原:只有反应原性,无免疫原性,和大小无关
• 颗粒抗原:细胞、细菌等有形成分
Q
mm12123
2026年03月07日 18:23
问题编号: 30495
除下列哪项外,NAP染色主要用于鉴别
A.慢性粒细胞白血病与类白血病反应
B.慢性细菌性感染
C.真性与继发性红细胞增多症
D.再生障碍性贫血与PNH
E.急性淋巴细胞白血病与急性粒细胞白血病
A.慢性粒细胞白血病与类白血病反应
B.慢性细菌性感染
C.真性与继发性红细胞增多症
D.再生障碍性贫血与PNH
E.急性淋巴细胞白血病与急性粒细胞白血病
问1:有题目解析里的第2点,那为啥不可以选A呢?
Q
az666
2026年03月07日 18:23
问题编号: 42270
患者,男,43岁。心前区剧烈疼痛1h就诊,心电图检查无异常,心肌肌钙蛋白、肌酸激酶同工酶、乳酸脱氢酶检查均正常,目前的处置方法适合的是
A. 马上复查心电图
B. 马上复查心肌肌钙蛋白、肌酸激酶同工酶、乳酸脱氢酶
C. 3~6个小时后再复查心肌肌钙蛋白、肌酸激酶同工酶、乳酸脱氢酶
D. 补充检查肌红蛋白
E. 患者正常无需处置
A. 马上复查心电图
B. 马上复查心肌肌钙蛋白、肌酸激酶同工酶、乳酸脱氢酶
C. 3~6个小时后再复查心肌肌钙蛋白、肌酸激酶同工酶、乳酸脱氢酶
D. 补充检查肌红蛋白
E. 患者正常无需处置
问1:答案有问题,病人1h检查其他的都是正常的,但是确实是出现症状,检查的项目不符合升高,肯定要添加检查肌红蛋白啊
Q
小彩子
2026年03月07日 18:16
问题编号: 42656
HCG检查作为葡萄胎和正常妊娠鉴别诊断的试验是
A.乳胶凝集抑制试验
B.胶体金免疫测定
C.红细胞凝集抑制稀释试验
D.胶乳凝集抑制稀释试验
E.hCG浓缩定量试验
A.乳胶凝集抑制试验
B.胶体金免疫测定
C.红细胞凝集抑制稀释试验
D.胶乳凝集抑制稀释试验
E.hCG浓缩定量试验
问1:老师,这个题有些资料选E
Q
az666
2026年03月07日 17:56
问题编号: 42242
患者,男,45岁。突然感觉胸痛,4小时后到医院就诊,心电图ST段抬高,以下哪项检查对于排除急性心肌梗死的首要指标
A. CK
B. CK-MB亚型
C. cTn
D. Mb
E. LDH
A. CK
B. CK-MB亚型
C. cTn
D. Mb
E. LDH
问1:没有M选项
Q
葫芦
2026年03月07日 17:55
问题编号: 42590
关于单向扩散试验平板法叙述,不正确的是
A.单向扩散试验平板法24~48h小时后可出现沉淀环
B.Mancini曲线适用于小分子抗原
C.Fahey曲线适用于小分子抗原
D.Mancini曲线适用于较长时间(>8h)扩散的结果
E.Fahey曲线适用于较短时间扩散的结果
A.单向扩散试验平板法24~48h小时后可出现沉淀环
B.Mancini曲线适用于小分子抗原
C.Fahey曲线适用于小分子抗原
D.Mancini曲线适用于较长时间(>8h)扩散的结果
E.Fahey曲线适用于较短时间扩散的结果
问1:没有解释
Q
张严
2026年03月07日 17:46
问题编号: 11601
如图2所示,尿液沉渣涂片中大结晶是

A.三联磷酸盐结晶
B.胱氨酸结晶
C.尿酸结晶
D.胆固醇结晶
E.马尿酸结晶

A.三联磷酸盐结晶
B.胱氨酸结晶
C.尿酸结晶
D.胆固醇结晶
E.马尿酸结晶
问1:提供图片
Q
17613922905
2026年03月07日 17:42
问题编号: 28626
患者,男,出生后1天,皮肤出现黄染住院。血型鉴定结果如图所示

该患者血型应该判定为
A.A型
B.B型
C.AB型
D.O型
E.不能判定

该患者血型应该判定为
A.A型
B.B型
C.AB型
D.O型
E.不能判定
问1:咋没说这个图卡咋看呢 也没提母亲啥学型
Q
张严
2026年03月07日 17:26
问题编号: 8632
下列符合革兰阴性杆菌尿路感染的诊断标准是
A.10^4CFU/L
B.10^5CFU/L
C.10^6CFU/L
D.10^7CFU/L
E.10^8CFU/L
A.10^4CFU/L
B.10^5CFU/L
C.10^6CFU/L
D.10^7CFU/L
E.10^8CFU/L
问1:这题是B
Q
张严
2026年03月07日 15:38
问题编号: 10736
[患者男性,21岁。咳嗽伴午后低热一月余。体检:体温37.9°C,呼吸音较粗,叩诊左肺清音界上移。实验室检查:WBC6.2X109/L,ESR96mm/h。X线检查显示左侧肋隔角消失。该患者无吸烟史。]
LD酶分子是由几个亚基组成的
A.2个
B.3个
C.4个
D.5个
E.6个
LD酶分子是由几个亚基组成的
A.2个
B.3个
C.4个
D.5个
E.6个
问1:两个亚基
Q
葫芦
2026年03月07日 14:18
问题编号: 42552
属于器官特异性肿瘤标志物的是
A.CEA
B.CA15-3
C.CA50
D.CA19-9
E.PSA
A.CEA
B.CA15-3
C.CA50
D.CA19-9
E.PSA
问1:什么特异性器官肿瘤标志物,怎么理解题目
Q
曾丽琼
2026年03月07日 14:04
问题编号: 38722
前列腺液约占精液的
A.10%
B.20%
C.30%
D.40%
E.60%
A.10%
B.20%
C.30%
D.40%
E.60%
问1:前列腺液到底是占30%还是60%
Q
曾丽琼
2026年03月07日 14:03
问题编号: 38723
人畜共患感染性疾病的致病菌属是
A.炭疽
B.鲍特菌属
C.嗜血杆菌属
D.巴斯德菌属
E.弗朗西斯菌属
A.炭疽
B.鲍特菌属
C.嗜血杆菌属
D.巴斯德菌属
E.弗朗西斯菌属
问1:为什么豆包上说这个答案是D
Q
张严
2026年03月07日 12:50
问题编号: 8688
反映肾浓缩稀释功能的最佳指标是
A.比密
B.渗透压
C.自由水清除率
D.电导率
E.尿渗量
A.比密
B.渗透压
C.自由水清除率
D.电导率
E.尿渗量
问1:这题应该是自由水清除率
Q
张严
2026年03月07日 00:35
问题编号: 11812
患者女,多次检查尿常规,均为镜下血尿,蛋白(+~++)。无尿频、尿急、尿痛。进一步检查尿红细胞形态,如图3所示,提示可能的诊断是[原图丢失,尿红细胞表现为不均一性血尿]
A.外伤
B.泌尿系统结石
C.肾源性血尿
D.膀胱炎
E.血友病
A.外伤
B.泌尿系统结石
C.肾源性血尿
D.膀胱炎
E.血友病
问1:没有图
Q
张严
2026年03月07日 00:30
问题编号: 11800
自动生化仪上,电极法快速检测血浆或血清葡萄糖依据的原理是
A.葡萄糖氧化酶-过氧化物酶偶联法
B.己糖激酶法
C.葡萄糖氧化酶-氧速率法
D.葡萄糖脱氢酶法
E.Folin-Wu法
A.葡萄糖氧化酶-过氧化物酶偶联法
B.己糖激酶法
C.葡萄糖氧化酶-氧速率法
D.葡萄糖脱氢酶法
E.Folin-Wu法
问1:答案没更正
Q
张严
2026年03月06日 20:01
问题编号: 10784
肉毒梭菌的致病毒素本质是一种
A.肠毒素
B.红疹毒素
C.外毒素
D.神经毒素
E.内毒素
A.肠毒素
B.红疹毒素
C.外毒素
D.神经毒素
E.内毒素
问1:肉毒素是神经毒素
Q
凤姐
2026年03月06日 17:32
问题编号: 43899
某患者血气分析结果为:pH7.12,PaCO225mmHg,HCO3-18mmol/L。应考虑为
A.呼吸性酸中毒伴代谢性酸中毒
B.呼吸性酸中毒伴代谢性碱中毒
C.呼吸性碱中毒伴代谢性酸中毒
D.呼吸性碱中毒伴代谢性碱中毒
E.代谢性酸中毒伴代谢性碱中毒
A.呼吸性酸中毒伴代谢性酸中毒
B.呼吸性酸中毒伴代谢性碱中毒
C.呼吸性碱中毒伴代谢性酸中毒
D.呼吸性碱中毒伴代谢性碱中毒
E.代谢性酸中毒伴代谢性碱中毒
问1:只明白ph低于正常值就是酸中毒。
Q
WyuEe
2026年03月06日 15:33
问题编号: 28956
如图所示为尿沉渣显微镜检查,图片中显示的细胞是

A.红细胞(G红细胞)
B.真菌孢子
C.白细胞
D.鳞状上皮细胞
E.血小板

A.红细胞(G红细胞)
B.真菌孢子
C.白细胞
D.鳞状上皮细胞
E.血小板
问1:G红细胞和真菌孢子怎么鉴别
Q
15859244249
2026年03月06日 15:17
问题编号: 42304
产气荚膜梭菌的a毒素是
A.溶血毒素
B.坏死毒素
C.肠毒素
D.卵磷脂酶
E.外毒素
A.溶血毒素
B.坏死毒素
C.肠毒素
D.卵磷脂酶
E.外毒素
问1:老师,您好!题目解析说外毒素以A毒素为主,那不是应该选E嘛?
Q
19984079271
2026年03月06日 14:39
问题编号: 34382
用肉眼可见即可判定抗原抗体反应结果的试验是
A.间接荧光免疫技术
B.凝集反应
C.化学发光技术
D.沉淀反应
E.电化学发光技术
A.间接荧光免疫技术
B.凝集反应
C.化学发光技术
D.沉淀反应
E.电化学发光技术
问1:D选项可溶性抗原与抗体结合也是产生肉眼可见的沉淀 为什么这个不对呢
Q
张严
2026年03月06日 13:09
问题编号: 10932
某烧伤患者实验室检查结果:WBC 12 X10^9/L,中性分叶核细胞 79%,中性杆状核细胞 8%,淋巴细胞 13%,血涂片发现中毒颗粒及空泡。嗜中性粒细胞增加的主要原因是
A.释放了成熟池粒细胞
B.释放了分裂池粒细胞
C.释放了贮备池细胞
D.边缘池粒细胞进入循环池
E.循环池粒细胞未进入边缘池
A.释放了成熟池粒细胞
B.释放了分裂池粒细胞
C.释放了贮备池细胞
D.边缘池粒细胞进入循环池
E.循环池粒细胞未进入边缘池
问1:答案是D吧
Q
张严
2026年03月06日 13:06
问题编号: 10918
患者男,30岁。头昏,乏力2年余,加重伴皮肤黄染1月入院。实验室检查:RBC 2.8X10^12/L,HB 50g/L,WBC 3.0X10^9/L,血小板 48X10^9/L,网织红细胞 20%,骨髓涂片如图1所示,尿胆红素(-),尿胆原1:320,尿含铁血黄素实验入图2所示。为明确诊断,最有必要再做哪项检查
A.Ham试验
B.Coombs试验
C.铁代谢检查
D.血红蛋白电泳
E.骨髓病理学检查
A.Ham试验
B.Coombs试验
C.铁代谢检查
D.血红蛋白电泳
E.骨髓病理学检查
问1:没有图